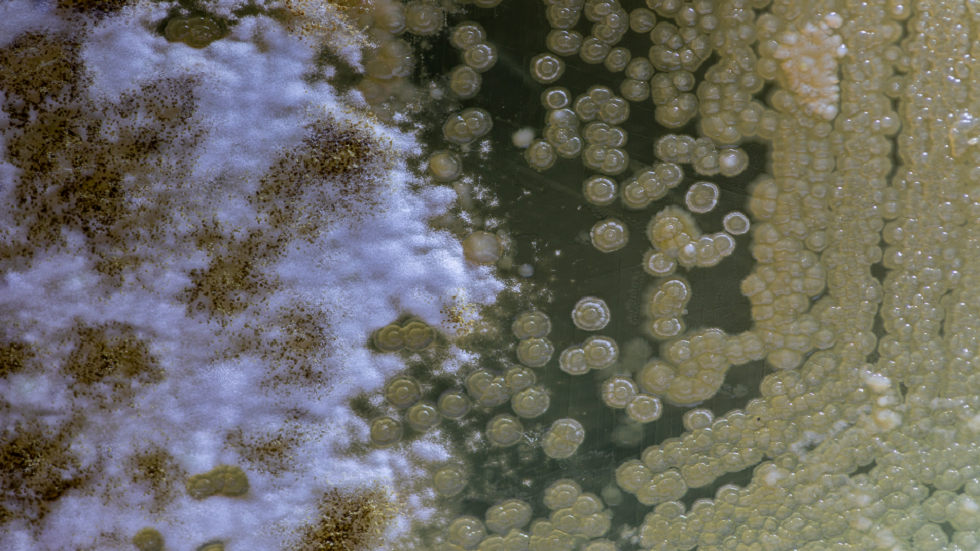
العلماء يحذرون من فيروس قاتل قد يطلق العنان له قريبا!

Stories
-
![مونديال 2026]()
مونديال 2026
RT STORIES
9 أرقام تاريخية يكتبها منتخب مصر بعد بلوغه دور خروج المغلوب في المونديال
![9 أرقام تاريخية يكتبها منتخب مصر بعد بلوغه دور خروج المغلوب في المونديال]() #اسأل_أكثر #Question_More
#اسأل_أكثر #Question_MoreRT STORIES
كندا تسجل هدفا "قاتلا" في شباك جنوب إفريقيا وتحجز بطاقة التأهل الأولى لدور الـ16 في مونديال 2026
![كندا تسجل هدفا "قاتلا" في شباك جنوب إفريقيا وتحجز بطاقة التأهل الأولى لدور الـ16 في مونديال 2026]() #اسأل_أكثر #Question_More
#اسأل_أكثر #Question_MoreRT STORIES
التشكيلة المثالية لدور المجموعات في كأس العالم 2026
![التشكيلة المثالية لدور المجموعات في كأس العالم 2026]() #اسأل_أكثر #Question_More
#اسأل_أكثر #Question_MoreRT STORIES
الإعلان الرسمي عن الصفقة بعد المونديال.. نجم منتخب مصر يتوصل لاتفاق للانتقال للدوري السعودي
![الإعلان الرسمي عن الصفقة بعد المونديال.. نجم منتخب مصر يتوصل لاتفاق للانتقال للدوري السعودي]() #اسأل_أكثر #Question_More
#اسأل_أكثر #Question_MoreRT STORIES
الاتحاد المصري يحسم موقف صلاح وعبد المنعم من المشاركة في مواجهة أستراليا
![الاتحاد المصري يحسم موقف صلاح وعبد المنعم من المشاركة في مواجهة أستراليا]() #اسأل_أكثر #Question_More
#اسأل_أكثر #Question_MoreRT STORIES
القارة السمراء تكتب التاريخ... 9 منتخبات إفريقية في دور الـ32 بالمونديال
![القارة السمراء تكتب التاريخ... 9 منتخبات إفريقية في دور الـ32 بالمونديال]() #اسأل_أكثر #Question_More
#اسأل_أكثر #Question_MoreRT STORIES
منتخب مصر يجني أول مكاسب التأهل إلى دور الـ32 في كأس العالم
![منتخب مصر يجني أول مكاسب التأهل إلى دور الـ32 في كأس العالم]() #اسأل_أكثر #Question_More
#اسأل_أكثر #Question_MoreRT STORIES
أول تعليق من المدرب جمال سلامي بعد وداع الأردن لكأس العالم 2026
![أول تعليق من المدرب جمال سلامي بعد وداع الأردن لكأس العالم 2026]() #اسأل_أكثر #Question_More
#اسأل_أكثر #Question_MoreRT STORIES
طبيب منتخب مصر يكشف تشخيص إصابة محمد صلاح
![طبيب منتخب مصر يكشف تشخيص إصابة محمد صلاح]() #اسأل_أكثر #Question_More
#اسأل_أكثر #Question_MoreRT STORIES
كندا وجنوب إفريقيا.. مواجهة تاريخية في افتتاح الأدوار الاقصائية لمونديال 2026
![كندا وجنوب إفريقيا.. مواجهة تاريخية في افتتاح الأدوار الاقصائية لمونديال 2026]() #اسأل_أكثر #Question_More
#اسأل_أكثر #Question_MoreRT STORIES
رد فعل زوجة ميسي وأبنائه بعد هدفه في شباك الأردن تخطف الأنظار (فيديو)
![رد فعل زوجة ميسي وأبنائه بعد هدفه في شباك الأردن تخطف الأنظار (فيديو)]() #اسأل_أكثر #Question_More
#اسأل_أكثر #Question_MoreRT STORIES
بعد أقل من أسبوعين على توليه المهمة.. التلفزيون التونسي يعلن رحيل رينارد
![بعد أقل من أسبوعين على توليه المهمة.. التلفزيون التونسي يعلن رحيل رينارد]() #اسأل_أكثر #Question_More
#اسأل_أكثر #Question_MoreRT STORIES
حزن في صفوف منتخب هولندا.. كودي خاكبو يواجه مأساة قبل لقاء المغرب
![حزن في صفوف منتخب هولندا.. كودي خاكبو يواجه مأساة قبل لقاء المغرب]() #اسأل_أكثر #Question_More
#اسأل_أكثر #Question_MoreRT STORIES
الاتحاد الإيراني يصدر بيانا بعد تأكد خروج منتخبه الأول من كأس العالم 2026
![الاتحاد الإيراني يصدر بيانا بعد تأكد خروج منتخبه الأول من كأس العالم 2026]() #اسأل_أكثر #Question_More
#اسأل_أكثر #Question_MoreRT STORIES
مونديال 2026.. مواجهة فاصلة بطعم الثأر بين البرازيل واليابان.. الموعد والقنوات الناقلة
![مونديال 2026.. مواجهة فاصلة بطعم الثأر بين البرازيل واليابان.. الموعد والقنوات الناقلة]() #اسأل_أكثر #Question_More
#اسأل_أكثر #Question_MoreRT STORIES
صدمة للمنتخب المصري.. انتهاء مشوار لاعب "الفراعنة" في كأس العالم 2026
![صدمة للمنتخب المصري.. انتهاء مشوار لاعب "الفراعنة" في كأس العالم 2026]() #اسأل_أكثر #Question_More
#اسأل_أكثر #Question_MoreRT STORIES
الذكاء الاصطناعي يتوقع الفائز في مباراة هولندا والمغرب
![الذكاء الاصطناعي يتوقع الفائز في مباراة هولندا والمغرب]() #اسأل_أكثر #Question_More
#اسأل_أكثر #Question_MoreRT STORIES
ترتيب هدافي كأس العالم بعد هدف ميسي أمام الأردن
![ترتيب هدافي كأس العالم بعد هدف ميسي أمام الأردن]() #اسأل_أكثر #Question_More
#اسأل_أكثر #Question_MoreRT STORIES
تعادل الجزائر والنمسا وإقصاء إيران يعيد شبح "فضيحة خيخون" إلى الواجهة
![تعادل الجزائر والنمسا وإقصاء إيران يعيد شبح "فضيحة خيخون" إلى الواجهة]() #اسأل_أكثر #Question_More
#اسأل_أكثر #Question_MoreRT STORIES
بعد وداع المونديال.. ما حقيقة "عقاب الطائرة" لنجوم أوروغواي؟
![بعد وداع المونديال.. ما حقيقة "عقاب الطائرة" لنجوم أوروغواي؟]() #اسأل_أكثر #Question_More
#اسأل_أكثر #Question_MoreRT STORIES
"رونالدو هو المشكلة".. تعليق تلفزيوني يشعل أزمة في مونديال 2026
!["رونالدو هو المشكلة".. تعليق تلفزيوني يشعل أزمة في مونديال 2026]() #اسأل_أكثر #Question_More
#اسأل_أكثر #Question_MoreRT STORIES
قمم مرتقبة.. مواعيد مباريات دور الـ32 في كأس العالم 2026
![قمم مرتقبة.. مواعيد مباريات دور الـ32 في كأس العالم 2026]() #اسأل_أكثر #Question_More
#اسأل_أكثر #Question_MoreRT STORIES
ميسي يحطم رقما قياسيا جديدا في كأس العالم 2026
![ميسي يحطم رقما قياسيا جديدا في كأس العالم 2026]() #اسأل_أكثر #Question_More
#اسأل_أكثر #Question_MoreRT STORIES
نهاية دور المجموعات.. تعرف على جميع المتأهلين في مونديال 2026
![نهاية دور المجموعات.. تعرف على جميع المتأهلين في مونديال 2026]() #اسأل_أكثر #Question_More
#اسأل_أكثر #Question_MoreRT STORIES
مودريتش يتفوق على مارادونا ويكتب رقما تاريخيا في المونديال
![مودريتش يتفوق على مارادونا ويكتب رقما تاريخيا في المونديال]() #اسأل_أكثر #Question_More
#اسأل_أكثر #Question_MoreRT STORIES
إنجاز مونديالي.. الكونغو الديمقراطية تكتب التاريخ في المجموعة الـ11
![إنجاز مونديالي.. الكونغو الديمقراطية تكتب التاريخ في المجموعة الـ11]() #اسأل_أكثر #Question_More
#اسأل_أكثر #Question_MoreRT STORIES
كولومبيا تحافظ على القمة.. والبرتغال تعبر إلى دور الـ32 من مركز الوصافة
![كولومبيا تحافظ على القمة.. والبرتغال تعبر إلى دور الـ32 من مركز الوصافة]() #اسأل_أكثر #Question_More
#اسأل_أكثر #Question_MoreRT STORIES
نبض اليوم الـ18.. كأس العالم 2026 يبدأ وجهه الحقيقي وانطلاق الأدوار الإقصائية
![نبض اليوم الـ18.. كأس العالم 2026 يبدأ وجهه الحقيقي وانطلاق الأدوار الإقصائية]() #اسأل_أكثر #Question_More
#اسأل_أكثر #Question_More![مونديال 2026]() مونديال 2026
مونديال 2026
-
![اتفاق أمريكي إيراني لوقف الحرب على جميع الجبهات]()
اتفاق أمريكي إيراني لوقف الحرب على جميع الجبهات
RT STORIES
IRIB: الحرس الثوري الإيراني قصف ليلة الأحد 8 قواعد أمريكية في الكويت والبحرين
![IRIB: الحرس الثوري الإيراني قصف ليلة الأحد 8 قواعد أمريكية في الكويت والبحرين]() #اسأل_أكثر #Question_More
#اسأل_أكثر #Question_MoreRT STORIES
واشنطن وطهران تتفقان على وقف الهجمات واستئناف المحادثات
![واشنطن وطهران تتفقان على وقف الهجمات واستئناف المحادثات]() #اسأل_أكثر #Question_More
#اسأل_أكثر #Question_MoreRT STORIES
"وول ستريت جورنال": تعليق المفاوضات بين واشنطن وطهران بعد تبادل الضربات
!["وول ستريت جورنال": تعليق المفاوضات بين واشنطن وطهران بعد تبادل الضربات]() #اسأل_أكثر #Question_More
#اسأل_أكثر #Question_MoreRT STORIES
عراقجي: إيران وحدها المسؤولة عن إدارة مضيق هرمز وأي تحرك منفرد سيؤدي للتصعيد
![عراقجي: إيران وحدها المسؤولة عن إدارة مضيق هرمز وأي تحرك منفرد سيؤدي للتصعيد]() #اسأل_أكثر #Question_More
#اسأل_أكثر #Question_MoreRT STORIES
الجيش الكويتي يعلن اعتراض صاروخين باليستيين
![الجيش الكويتي يعلن اعتراض صاروخين باليستيين]() #اسأل_أكثر #Question_More
#اسأل_أكثر #Question_MoreRT STORIES
الجيش الإيراني: سيطرتنا على هرمز قد تؤدي تدريجيا لإخراج واشنطن من المنطقة
![الجيش الإيراني: سيطرتنا على هرمز قد تؤدي تدريجيا لإخراج واشنطن من المنطقة]() #اسأل_أكثر #Question_More
#اسأل_أكثر #Question_MoreRT STORIES
البحرين تدين "تجدد الاعتداء الإيراني" على أراضيها وتدعو لتحرك دولي لوقفه
![البحرين تدين "تجدد الاعتداء الإيراني" على أراضيها وتدعو لتحرك دولي لوقفه]() #اسأل_أكثر #Question_More
#اسأل_أكثر #Question_MoreRT STORIES
البحرين تطلق صفارات الإنذار للمرة الثانية تحسبا لهجوم إيراني
![البحرين تطلق صفارات الإنذار للمرة الثانية تحسبا لهجوم إيراني]() #اسأل_أكثر #Question_More
#اسأل_أكثر #Question_MoreRT STORIES
"الوضع لا يزال غير واضح".. مسؤول أمريكي يؤكد استهداف إيران لمنشآت أمريكية في البحرين والكويت
!["الوضع لا يزال غير واضح".. مسؤول أمريكي يؤكد استهداف إيران لمنشآت أمريكية في البحرين والكويت]() #اسأل_أكثر #Question_More
#اسأل_أكثر #Question_MoreRT STORIES
الجيش الأمريكي يعلن شن ضربات على 10 مواقع بمضيق هرمز
![الجيش الأمريكي يعلن شن ضربات على 10 مواقع بمضيق هرمز]() #اسأل_أكثر #Question_More
#اسأل_أكثر #Question_More![اتفاق أمريكي إيراني لوقف الحرب على جميع الجبهات]() اتفاق أمريكي إيراني لوقف الحرب على جميع الجبهات
اتفاق أمريكي إيراني لوقف الحرب على جميع الجبهات
-
![العملية العسكرية الروسية في أوكرانيا]()
العملية العسكرية الروسية في أوكرانيا
RT STORIES
بوتين: لم يتم توقيع أي شيء خلال القمة مع ترامب في أنكوريج وروسيا مستعدة لمواصلة المحادثات
![بوتين: لم يتم توقيع أي شيء خلال القمة مع ترامب في أنكوريج وروسيا مستعدة لمواصلة المحادثات]() #اسأل_أكثر #Question_More
#اسأل_أكثر #Question_MoreRT STORIES
بوتين يكشف عن مقترح أوكراني لحصر القتال بأربع مناطق ويؤكد: لن نسمح بتعليق تقدمنا
![بوتين يكشف عن مقترح أوكراني لحصر القتال بأربع مناطق ويؤكد: لن نسمح بتعليق تقدمنا]() #اسأل_أكثر #Question_More
#اسأل_أكثر #Question_MoreRT STORIES
الدفاعات الجوية الروسية تدمر 72 مسيرة جوية معادية خلال 12 ساعة فوق عدة مناطق
![الدفاعات الجوية الروسية تدمر 72 مسيرة جوية معادية خلال 12 ساعة فوق عدة مناطق]() #اسأل_أكثر #Question_More
#اسأل_أكثر #Question_MoreRT STORIES
دبلوماسي بريطاني: صمت إعلام لندن تجاه تصرفات عناصر مراكز التعبئة في أوكرانيا أمر مخز
![دبلوماسي بريطاني: صمت إعلام لندن تجاه تصرفات عناصر مراكز التعبئة في أوكرانيا أمر مخز]() #اسأل_أكثر #Question_More
#اسأل_أكثر #Question_MoreRT STORIES
مستشار أوكراني: تصريح زوجة كوليبا حول ضربة نووية لأوكرانيا تعكس موقف كييف
![مستشار أوكراني: تصريح زوجة كوليبا حول ضربة نووية لأوكرانيا تعكس موقف كييف]() #اسأل_أكثر #Question_More
#اسأل_أكثر #Question_MoreRT STORIES
الجيش الروسي يحرر بلدتين شرق وجنوب أوكرانيا (فيديو)
![الجيش الروسي يحرر بلدتين شرق وجنوب أوكرانيا (فيديو)]() #اسأل_أكثر #Question_More
#اسأل_أكثر #Question_MoreRT STORIES
وزير الخارجية البولندي: مستعدون لخوض مواجهة عسكرية مع روسيا
![وزير الخارجية البولندي: مستعدون لخوض مواجهة عسكرية مع روسيا]() #اسأل_أكثر #Question_More
#اسأل_أكثر #Question_MoreRT STORIES
الدفاع الروسية: إسقاط 213 مسيرة أوكرانية غربي البلاد
![الدفاع الروسية: إسقاط 213 مسيرة أوكرانية غربي البلاد]() #اسأل_أكثر #Question_More
#اسأل_أكثر #Question_MoreRT STORIES
قتيل ومصاب وحريق بمصفاة للنفط بهجوم مسيرات أوكرانية جنوب روسيا
![قتيل ومصاب وحريق بمصفاة للنفط بهجوم مسيرات أوكرانية جنوب روسيا]() #اسأل_أكثر #Question_More
#اسأل_أكثر #Question_MoreRT STORIES
أوكرانيا تأمل في الحصول على 154 مليار دولار إضافية من حلفائها الغربيين قبل 2030
![أوكرانيا تأمل في الحصول على 154 مليار دولار إضافية من حلفائها الغربيين قبل 2030]() #اسأل_أكثر #Question_More
#اسأل_أكثر #Question_More![العملية العسكرية الروسية في أوكرانيا]() العملية العسكرية الروسية في أوكرانيا
العملية العسكرية الروسية في أوكرانيا
-
![إسرائيل ولبنان يتوصلان إلى اتفاق إطار]()
إسرائيل ولبنان يتوصلان إلى اتفاق إطار
RT STORIES
حزب الله يتعهد باسقاط "الاتفاق الإطاري" بين لبنان وإسرائيل ويحدد خطوطا حمراء
![حزب الله يتعهد باسقاط "الاتفاق الإطاري" بين لبنان وإسرائيل ويحدد خطوطا حمراء]() #اسأل_أكثر #Question_More
#اسأل_أكثر #Question_MoreRT STORIES
"ظل سريا بناء على طلب من بيروت".. قناة عبرية تنشر أبرز بنود الملحق الأمني السري للاتفاقية مع لبنان
!["ظل سريا بناء على طلب من بيروت".. قناة عبرية تنشر أبرز بنود الملحق الأمني السري للاتفاقية مع لبنان]() #اسأل_أكثر #Question_More
#اسأل_أكثر #Question_MoreRT STORIES
مصر تحدد "مفتاح الاستقرار" في لبنان بعد اتفاق الإطار مع إسرائيل
![مصر تحدد "مفتاح الاستقرار" في لبنان بعد اتفاق الإطار مع إسرائيل]() #اسأل_أكثر #Question_More
#اسأل_أكثر #Question_MoreRT STORIES
خلف الكواليس.. كيف أدى الخوف المشترك من إيران إلى اتفاق إسرائيلي لبناني؟
![خلف الكواليس.. كيف أدى الخوف المشترك من إيران إلى اتفاق إسرائيلي لبناني؟]() #اسأل_أكثر #Question_More
#اسأل_أكثر #Question_MoreRT STORIES
بري لقاليباف: الاتفاق الإطاري بين لبنان واسرائيل مؤامرة وفتنة
![بري لقاليباف: الاتفاق الإطاري بين لبنان واسرائيل مؤامرة وفتنة]() #اسأل_أكثر #Question_More
#اسأل_أكثر #Question_MoreRT STORIES
صحيفة عبرية تهاجم قطر وباكستان.. "آلية منع الاحتكاك" خطأ استراتيجي يوقع إسرائيل بفخ لبنان
![صحيفة عبرية تهاجم قطر وباكستان.. "آلية منع الاحتكاك" خطأ استراتيجي يوقع إسرائيل بفخ لبنان]() #اسأل_أكثر #Question_More
#اسأل_أكثر #Question_MoreRT STORIES
"الغرفة المشتركة".. صدمة في إسرائيل ونتنياهو يدرس مهاجمة ترامب
!["الغرفة المشتركة".. صدمة في إسرائيل ونتنياهو يدرس مهاجمة ترامب]() #اسأل_أكثر #Question_More
#اسأل_أكثر #Question_MoreRT STORIES
نائب عن "حزب الله": معادلتنا تمتد من هرمز إلى باب المندب وعلي الطاهر
![نائب عن "حزب الله": معادلتنا تمتد من هرمز إلى باب المندب وعلي الطاهر]() #اسأل_أكثر #Question_More
#اسأل_أكثر #Question_MoreRT STORIES
الجيش الإسرائيلي يعلن تصفية عنصرين بـ"حزب الله" في جنوب لبنان (فيديو)
![الجيش الإسرائيلي يعلن تصفية عنصرين بـ"حزب الله" في جنوب لبنان (فيديو)]() #اسأل_أكثر #Question_More
#اسأل_أكثر #Question_MoreRT STORIES
بعد "الاتفاق الإطاري" مع لبنان.. نتنياهو يعرض المناطق التي ستبدأ فيها المرحلة التجريبية (صورة)
![بعد "الاتفاق الإطاري" مع لبنان.. نتنياهو يعرض المناطق التي ستبدأ فيها المرحلة التجريبية (صورة)]() #اسأل_أكثر #Question_More
#اسأل_أكثر #Question_MoreRT STORIES
"هآرتس": بنود "الاتفاق الإطار" الموقع في واشنطن تمهد الطريق لتحويل جنوب لبنان إلى "غزة 2"
!["هآرتس": بنود "الاتفاق الإطار" الموقع في واشنطن تمهد الطريق لتحويل جنوب لبنان إلى "غزة 2"]() #اسأل_أكثر #Question_More
#اسأل_أكثر #Question_More![إسرائيل ولبنان يتوصلان إلى اتفاق إطار]() إسرائيل ولبنان يتوصلان إلى اتفاق إطار
إسرائيل ولبنان يتوصلان إلى اتفاق إطار
-
فيديوهات
RT STORIES
الهند.. اصطدام العربة بسلك كهربائي أثناء مراسم دينية في ولاية ماديا براديش
#اسأل_أكثر #Question_MoreRT STORIES
الجيش الإسرائيلي يعلن عن استهداف قائد الشرطة البحرية التابعة لمنظمة "حماس"
#اسأل_أكثر #Question_MoreRT STORIES
اليابان.. مشاهد لزلزال في جزيرة هونشو بقوة 6.1 درجة
#اسأل_أكثر #Question_MoreRT STORIES
الحرس الثوري ينشر مشاهد للحظة إطلاق الصواريخ ردا على الهجمات الأمريكية
#اسأل_أكثر #Question_MoreRT STORIES
ألمانيا.. برلين تواجه موجة الحر بخراطيم المياه
#اسأل_أكثر #Question_MoreRT STORIES
روسيا.. إعصار مهيب يظهر فوق البحر الأسود في إقليم كراسنودار
#اسأل_أكثر #Question_Moreفيديوهات
-
![ضربة موجعة لـ"الفراعنة".. طبيب منتخب مصر يؤكد تعرض نجم الفريق لتمزق عضلي]()
ضربة موجعة لـ"الفراعنة".. طبيب منتخب مصر يؤكد تعرض نجم الفريق لتمزق عضلي
RT STORIES
ضربة موجعة لـ"الفراعنة".. طبيب منتخب مصر يؤكد تعرض نجم الفريق لتمزق عضلي
![ضربة موجعة لـ"الفراعنة".. طبيب منتخب مصر يؤكد تعرض نجم الفريق لتمزق عضلي]() #اسأل_أكثر #Question_More
#اسأل_أكثر #Question_More
القطب الشمالي يحطّم أرقاما قياسية مناخية في عام 2023!
حطّم عام 2023 الرقم القياسي للصيف الأكثر دفئا في القطب الشمالي، الذي أثر على الناس والنظم البيئية في جميع أنحاء المنطقة.

وتسببت حرائق الغابات بانطلاق عمليات الإخلاء في جميع أنحاء كندا. كما كانت غرينلاند حارّة جدا لدرجة أن محطة أبحاث في قمة الغطاء الجليدي سجلت ذوبانا في أواخر يونيو، ليكون حدث الذوبان الخامس المسجل.
وبدأ العام رطبا على غير العادة، وكان تراكم الثلوج خلال شتاء 2022-2023 أعلى من المتوسط في معظم أنحاء القطب الشمالي. ولكن بحلول شهر مايو، أدت درجات الحرارة المرتفعة في فصل الربيع إلى انخفاض الكتلة الثلجية في أمريكا الشمالية إلى مستوى قياسي، ما أدى إلى كشف اليابسة التي سرعان ما ارتفعت درجة حرارتها وجفت، ما أدى إلى تأجيج الحرائق التي أشعلها البرق في جميع أنحاء كندا.
وفي بطاقة تقرير القطب الشمالي لعام 2023، التي صدرت في 12 ديسمبر، جُمع 82 عالما في القطب الشمالي من جميع أنحاء العالم لتقييم العلامات الحيوية للقطب الشمالي، والتغيرات الجارية وتأثيراتها على الحياة في جميع أنحاء المنطقة وحول العالم.
وحطم صيف 2023 – يوليو وأغسطس وسبتمبر – الرقم القياسي السابق المسجل في عام 2016، بأربعة أضعاف ذلك الرقم. وكانت درجات الحرارة في كل مكان تقريبا في القطب الشمالي أعلى من المعدل الطبيعي.

علماء: انبعاثات ثاني أكسيد الكربون في مدن القطب الشمالي تزيد بنسبة 30% عنها في التربة الطبيعية
وذاب الغطاء الثلجي الشتوي مبكرا عبر أجزاء كبيرة من شمال كندا، ما أتاح للشمس شهرا إضافيا لرفع حرارة الأرض المكشوفة. وتؤدي الحرارة ونقص الرطوبة إلى تجفيف المواد العضوية الموجودة على السطح وتحته مباشرة.
كما أدى الطقس الدافئ للغاية في شهري مايو ويونيو 2023 في الأقاليم الشمالية الغربية، إلى تسخين نهر ماكنزي العظيم، ما أدى إلى إرسال كميات هائلة من المياه الدافئة إلى بحر بوفورت في الشمال.
وأذابت المياه الدافئة الجليد البحري في وقت مبكر، وحملته التيارات أيضا غربا نحو ألاسكا، حيث ساهمت مياه نهر ماكنزي في فقدان الجليد البحري مبكرا على طول معظم شمال شرق ألاسكا، وفي زيادة نمو نباتات التندرا.
كما ساهم الدفء المماثل في غرب سيبيريا في ذوبان الجليد البحري بسرعة، وارتفاع درجات حرارة سطح البحر في بحر كارا ولابتيف شمال روسيا.
وكان انخفاض الجليد البحري في القطب الشمالي مساهما كبيرا في الزيادة الهائلة في متوسط درجات حرارة الخريف في جميع أنحاء المنطقة.
ويتضمن التقرير 12 مقالة تستكشف آثار تغيرات المناخ والنظام البيئي عبر القطب الشمالي وكيفية تكيف المجتمعات.
وكشف عن التربة الصقيعية تحت سطح البحر، وهي تربة متجمدة في قاع المحيط غنية بالمواد العضوية. وبدأت تذوب تدريجيا منذ أن غمرتها المياه بعد تراجع الصفائح الجليدية في نصف الكرة الشمالي منذ آلاف السنين.
واليوم، من المرجح أن تؤدي درجات حرارة المحيط الأكثر دفئا إلى تسريع ذوبان هذه التربة الصقيعية المخفية.
العلماء يحذرون من فيروس قاتل قد يطلق العنان له قريبا!
وكما هو الحال مع التربة الصقيعية على الأرض، عندما تذوب التربة الصقيعية تحت سطح البحر، تتحلل المادة العضوية التي تحتوي عليها وتطلق غاز الميثان وثاني أكسيد الكربون، وتؤدي إلى تفاقم تحمض المحيطات.
وبالنسبة للعديد من الأشخاص الذين يعيشون في القطب الشمالي، يؤدي تغير المناخ بالفعل إلى تعطيل الحياة وسبل العيش.
وقد لاحظ المراقبون تحولات في أنماط الرياح والعواصف المحيطية الشديدة بشكل متزايد. وعلى الأرض، يؤدي ارتفاع درجات الحرارة إلى جعل الجليد النهري أقل موثوقية للسفر، كما يؤدي ذوبان التربة الصقيعية إلى غرق الطرق وزعزعة استقرار المنازل.
وشهدت مجتمعات ألاسكا الغربية التي تعتمد على سمك السلمون عاما آخر من الانخفاض الشديد في أعداد السمك في عام 2023، وهي ندرة تعطل الممارسات الثقافية والأمن الغذائي.
وتعد بطاقة تقرير القطب الشمالي لعام 2023 بمثابة تذكير بالمخاطر التي ينطوي عليها الأمر، سواء المخاطر الناجمة عن ارتفاع درجة حرارة الكوكب، أو الحياة والثقافات التي تعطلت بالفعل بسبب تغير المناخ.
التقرير من إعداد ريك تومان، أخصائي المناخ في ألاسكا، وماثيو دروكنميلر، عالم الأبحاث، وتويلا مون، نائب العالم الرئيسي، من المركز الوطني لبيانات الثلوج والجليد (NSIDC)، المعهد التعاوني لأبحاث العلوم البيئية (CIRES)، في جامعة كولورادو بولدر.
المصدر: ساينس ألرت
إقرأ المزيد

عالم روسي: ستصبح حرارة القطب الشمالي أعلى بمقدار 3-4 درجات مع نهاية القرن الحالي
يشير بافل توروبوف الأستاذ المشارك بكلية الجغرافيا بجامعة موسكو إلى أن الحرارة في القطب الشمالي ستصبح في نهاية القرن الحالي أعلى بمقدار 3-4 درجات عن مستواها الحالي.













































































































































































التعليقات